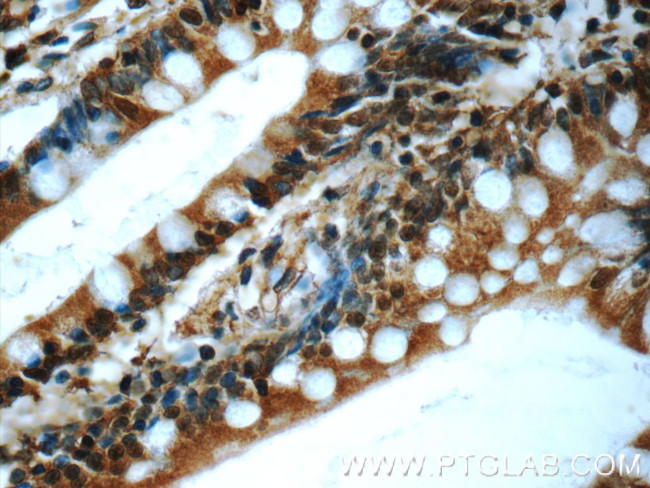
C20orf194 Antibody in Immunohistochemistry (Paraffin) (IHC (P))

Search
Proteintech
C20orf194 Polyclonal Antibody
{{$productOrderCtrl.translations['antibody.pdp.commerceCard.promotion.promotions']}}
{{$productOrderCtrl.translations['antibody.pdp.commerceCard.promotion.viewpromo']}}
{{$productOrderCtrl.translations['antibody.pdp.commerceCard.promotion.promocode']}}: {{promo.promoCode}} {{promo.promoTitle}} {{promo.promoDescription}}. {{$productOrderCtrl.translations['antibody.pdp.commerceCard.promotion.learnmore']}}
产品信息
23184-1-AP
种属反应
宿主/亚型
分类
类型
抗原
偶联物
形式
浓度
纯化类型
保存液
内含物
保存条件
运输条件
产品详细信息
Immunogen sequence: GYTDVIDVV QALQTHPDSN VKASFTIGAI TACVEPMSCY MEHRFLFPKC LDQCSQGLVS NVVFTSHTTE QRHPLLVQLQ SLIRAANPAA AFILAENGIV TRNEDIELIL SENSFSSPEM LRSRYLMYPG WYEGKLNAGS VYPLMVQICV WFGRPLEKTR FVAKCKAIQS SIKPSPFSGN IYHILGKVKF SDSERTMEVC YNTLANSLSI MPVLEGPTPP PDSKSVSQDS SGQQECYLVF IGCSLKEDSI KDWLRQSAKQ KPQRKALKTR GMLTQQEIRS IHVKRHLEPL PAGYFYNGTQ FVNFFGDKTD FHPLMDQFMN DYVEEANREI EKYNQELEQQ EYHDLFELKP (828-1177 aa encoded by BC122529)
靶标信息
The function of the C20orf194 gene has not yet been determined.
仅用于科研。不用于诊断过程。未经明确授权不得转售。
篇参考文献 (0)
生物信息学
蛋白别名: DNAAF9; Dynein axonemal assembly factor 9; uncharacterized protein C20orf194 homolog
基因别名: C20orf194; DNAAF9
UniProt ID: (Human) Q5TEA3
Entrez Gene ID: (Human) 25943, (Rat) 499891